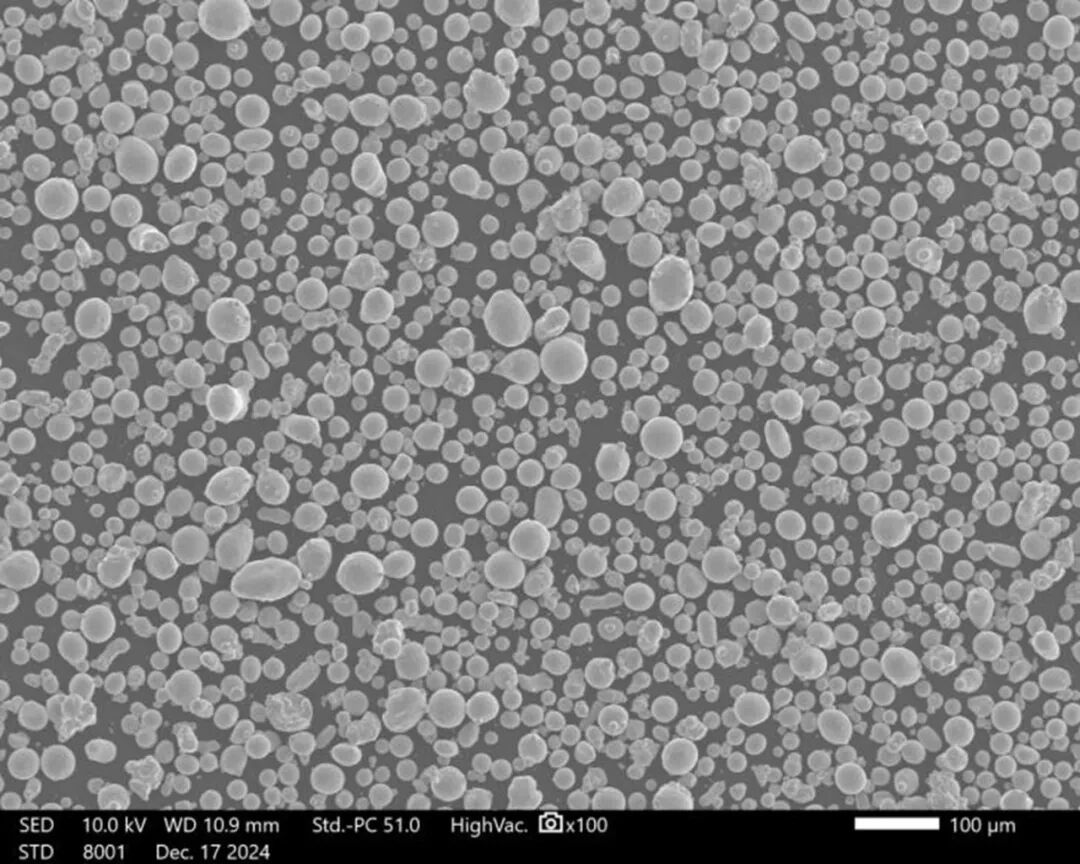

铜材3D打印重要指南:一篇看懂高导纯Cu/CuSn10/CuCrZr怎么选
电子通信、航空航天、能源装备......当下,各类高端装备的性能提升,离不开关键金属部件的持续优化。无论是提升导电导热性能,还是兼顾强度与耐腐蚀性,一切的创新都始于材料的精准适配。
凭借在铜3D打印领域的深厚积累与完善的工艺开发体系,希禾增材长期为行业提供三款成熟的绿激光增材制造解决方案:Cu、CuSn10、CuCrZr。三种铜材分别面向高导热、耐腐蚀与高温性能等核心需求,为关键部件的设计与制造提供可靠支撑。
高纯铜粉末 | 导电导热的理想之选

希禾增材采用气雾化技术制备的高纯铜粉末,具备极高的纯度与极低氧含量(≤300ppm),确保打印部件具备接近理论值的导电导热性能。

-
材料性能:
-
致密度:≥99.8%(排水法)
-
导电率:≥98.5%IACS(打印态);≈101.5% IACS(退火态)
-
抗拉强度:240 MPa
-
延伸率:30%
-
热导率:390-400 W/(m·K)
-
优势特点:
高纯度、低氧含量、粉末流动性良好(≤20s/50g),保证打印过程稳定,适用于高精度与复杂结构的成型。
-
应用领域:

散热器、冷板、新能源汽车零部件、电子元件、高频感应线圈等
CuSn10 | 强韧耐蚀,美观耐用

CuSn10凭借10wt.%锡的添加,在保持良好导电性的同时,显著提升材料强度和弹性,尤其适合海洋工程及装饰类应用。
-
材料性能:
-
致密度:≥99.8%(排水法)
-
抗拉强度:≥520 MPa
-
屈服强度:≥330 MPa
-
延伸率:≥28%
-
热导率:50-60 W/(m·K)
-
优势特点:
CuSn10粉末不仅具备优异的耐腐蚀性,还能良好适配厚层打印,实现高效率、低成本制造。
-
应用领域:

珠宝、装饰品、海洋装备部件、耐磨结构件等
CuCrZr | 高温高强,综合性能之王

CuCrZr在高温环境下仍保持优异的导电性与力学性能,是高温、高负荷工况下的实力担当。

-
材料性能:
-
致密度:≥99.8%(排水法)
-
导电率:≥90.0%IACS(热处理后)
-
抗拉强度:510 MPa
-
屈服强度:410 MPa
-
延伸率:20%
-
热导率:250-320 W/(m·K)
-
优势特点:
高温下性能稳定,强度与导电性俱佳。
-
应用领域:

火箭推力室、燃烧室、感应线圈、高强度连接器等。
三款铜材如何选?
在导电导热、结构强度及耐腐蚀性能等多重需求之间,材料的选择始终至关重要。希禾增材专注金属3D打印领域,依托完善的工艺体系与严格的质量管理,为不同应用场景提供成熟的解决方案。针对高反、难熔及常规金属材料的增材制造,公司绿光设备与打印工艺均经过长期验证,可实现高致密度、优异表面质量及稳定生产。#增材制造 #3D打印